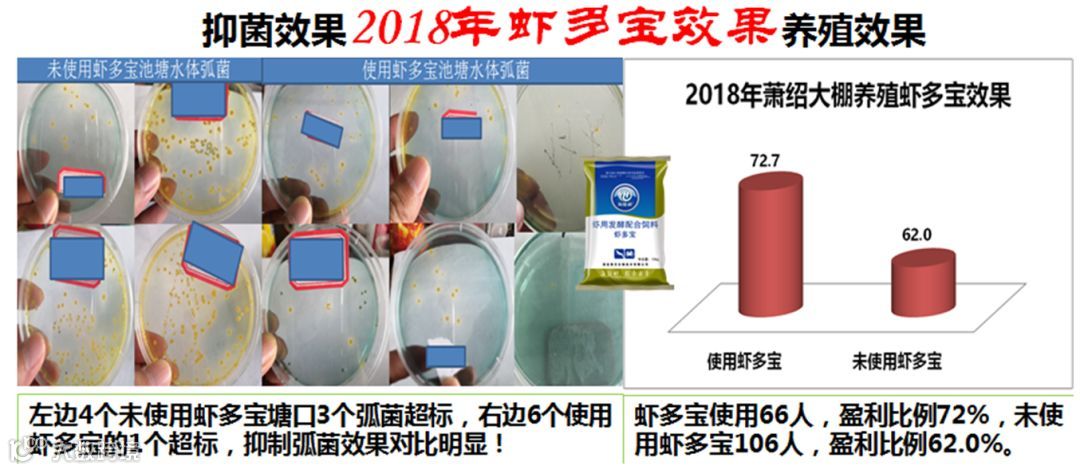

文 | 图 浙江海大 张慧
养虾——顾名思义就是依靠人工管理将虾苗养大。很简单的一句话,一件事,但就只说投喂管理一块,就有不少人并不全面了解饲料,包括饲料的分类,养殖各阶段怎样选择不同型号、营养的饲料,养殖过程中怎样合理投喂等等。
通过本文让我们一起了解投喂管理,在以后的养殖过程中能够做到细致科学。


饲料投喂掌握了这些你才会是一名合格的养虾人。
一、饲料的选择
1.1 饲料
能够被动物摄取、消化、吸收和利用的促进动物正常生长的食物都称为饲料。
饲料为动物的一切生命活动提供营养物质,在现代养殖业发展迅猛的时期,饲料加工业、饲料配方也有着多样化、科学化的发展。
1.2 水产饲料及分类
所有水生动物的饲料笼统地称为水产饲料。水产饲料如按其饲喂对象可分为对虾饲料、甲鱼饲料、青鱼饲料、混养饲料等等数万种。
(1)按水产饲料的加工方法及饲料的形态来分类,则水产饲料大致可分为以下几类:
① 硬颗粒饲料
② 膨化颗粒饲料
③ 粉末饲料
④ 破碎饲料
⑤ 软颗粒饲料


对虾养殖,不同阶段选择不同型号的饲料,苗场育苗配合天然饵料以及虾片等。苗期投喂虾片(0.8cm以下)、1cm以上投喂粉末饲料,2.5cm以上投喂破碎料直到对虾4-5cm时可以开始转颗粒料。因为对虾属于抱食、啃食,粒径太小,钳端饲料易滑落,这样会造成摄食能耗增加,速度慢。所以同等规格的对虾,投喂粒径不同的饲料其摄食时间也不同。按适口性匹配不同型号饲料,“通常对虾眼睛有多大就能摄食多大颗粒的饲料”。

(2)按主要成分划分,可以分为:
① 淀粉饲料
② 含油饲料
③ 绿色饲料
④ 含糖饲料
⑤ 含蛋白饲料
3、蛋白饲料
蛋白饲料是指饲料干物质中粗蛋白含量20%以上,粗纤维含量在18%以下的饲料。人工精养一般都是选择蛋白饲料,蛋白饲料又分为植物性蛋白饲料和动物性蛋白饲料。不过水产养殖加工饲料配方都会采用动物蛋白和植物蛋白取均衡营养成分。
蛋白质含量较高的植物性蛋白饲料有:豆粕、菜籽、花生、芝麻等饼粕,粗蛋白含量一般在30--45%。动物性蛋白饲料有:鱼粉、肉骨粉、血粉、蚕蛹、羽毛粉、蝇蛆、黄粉虫等,蛋白质含量一般在50--80%之间。


4、对虾养殖对蛋白含量的需求
水产饲料的蛋白质含量普遍要求比禽畜饲料的蛋白质含量高得多,只有这样才能保证鱼虾的营养需求。每100g对虾中含有蛋白质 (18.60g)、碳水化合物 (2.80g)、水分77g,其中蛋白质占有18.6%的比例。对虾生长所需的能量主要从蛋白质获得,蛋白质是构成虾体的主要成分。
用不同蛋白质水平(16. 16%、24. 26%、32. 70%、44. 12%、 51. 26%)的饲料投喂南美白对虾做试验,当饲料中粗蛋白为44.12%时,南美白对虾增重、增长及生长速度均为最大值,饵料系数最小。(湛江海洋大学水产学院 524025,李广丽等“不同蛋白质水平的饲料对南美白对虾生长的影响”)

李广丽等“不同蛋白质水平的饲料对南美白对虾生长的影响”
如浙江海大一款43蛋白的“虾多富”饲料,在2018年大棚养殖数据统计中在增重上比市场平均以及海大其它饲料优势明显(下图)。

正常养殖中南美白对虾对蛋白需求的量有所不同,通常在苗期(0.5-3cm)需求高蛋白,在生长高峰期需要高蛋白(5-10cm)。
所以在养殖中要合理选择对虾蛋白性饵料,苗期使用虾片及开口料,生长快速期需要投喂蛋白含量43%以上饲料达到缩短养殖周期,提早上市的目的。延长养殖时间,就需要控料、投喂43%以下饲料确保对虾健康稳定生长。
二、投喂管理
饲料选择有了概念,真正的技术点高要求是投喂管理方面的操作,这一过程贯穿整个养殖期。有专家指出,“白对虾养殖疾病的爆发往往与饲料的选择和投喂操作有着直接的联系”。饲料不合适,投喂不合理不仅造成污染还对对虾的正常摄食有一定的影响。选择好了饲料只是成功的第一步,准确投喂才能养好虾。
同样的情况下,为什么有的虾塘对虾吃料慢,有的吃料却快?同样调水改底的情况下,为什么有的虾塘亚盐高的早?……这些都可能与饲料投喂相关,所以合理投喂管理是养好虾的一大因素。
2.1 投喂管理 5 大关键要诀
养殖中投喂饲料要把握一个准字,要做到足、控、减、停、加五个字。
① 足:即是早起投喂要足够,因为对虾小苗期营养需求大,饲料总量少,不至于浪费,污染水质,投喂宁愿多而不能少;
② 控:对虾摄食较快量多时要适度的控制,如转肝后、高温天,此时控料能降低对虾消化负荷;
③ 减:吃料慢、蜕壳期、水质恶化以及天气变化等情况下要适当减料,避免过多饲料浪费且摄食时间过长,摄入有害菌多;
④ 停:对虾发病,如空肠空胃、偷死等情况下选择停料;
⑤ 加:根据料台,刮底查料,若第一餐很快吃完,第二餐适当加料或者正常情况下按比例加料。
2.2 日常管理中投喂管理操作
投喂餐数及时间
① 傍晚一餐多喂,对虾一般也属于昼伏夜出的生态习性,目前人工养殖驯化后虽然白天投喂饲料,但是合理的投喂餐数及饲料比例仍然建议3餐,(市场外塘养殖多数2餐,大棚3餐)早中晚比例为3:3:4。
② 投喂时间合理,池塘溶氧量的多少直接影响对虾摄食,早上6点前溶氧比较低,此时对虾活动受影响,所以建议投喂时间这样安排:早上7点前后、中午12点前后、傍晚5点前后。
① 数据模型参考:
从日投饵率估算投喂量,根据池塘对虾的总重,按照总重量的2-10%来作为每天的投喂量进行餐数分配后投喂。匹配对虾规格的大小按照1-6%的比例增料(下图)。

② 日常观察修正投喂量:
养殖情况多变,按照数据模型投喂收到的影响较大,平时应根据料台、查料、对虾的饱食率进行灵活修正投喂。
吃料时间观察:

粪便观察:
粪便长度约3cm左右且颜色与饲料颜色一致,则说明投料量是够的;若粪便长度过短且颜色为黑褐色,则说明投料量是不足的。


3、投喂方式及拌料
① 前期足料、中后期控料。平时投喂最好整个虾塘四周投喂,饲料要分散开,均匀并距离岸边1.5米以上。确保对虾正常摄食,不会因聚集而出现部分虾吃不到料的情况。
② 投喂拌料更要合理。苗期及前期多维多矿、活菌拌料增强体质、改善肠道,转肝期拌料转肝相关产品,促进对虾快速高比例转肝,中后期定期拌料有益菌、补钙及维生素等产品预防细菌感染。
三、小结及建议
选择饲料明在前,合理搭配操作中。投喂管理要科学,足控减停加合理。
记得去年部分养户朋友池塘出现料比2以上,也就是投喂了2斤料产出1斤虾,这是明显的投喂失误,没有那么多的虾了,眼看着料能吃完就闷着头喂下去,结果鲫鱼抓了很多,虾却没有多少。这样的例子不在少数,每年因为投喂管理失误造成损失的池塘都有很多。
所以,日常投喂管理关系到整个养殖过程。投喂过多造成浪费,不仅对虾负荷大易发病,残饵粪便更是致病菌的养料、氨氮亚盐飙升、底质恶化以及蓝藻爆发等等。投喂过少则规格差异大,产量较低、卖虾晚没价格。
投喂是一门技术活,只有合理科学投喂,选择对了饲料才能更大程度的提高养殖成功率。
附:虾多宝发酵料的使用
1、为什么要使用发酵饲料?
养殖过程中,饲料和养殖动物不断增加,肠道不健康,饲料利用率降低,粪便的污染加剧,水体的碳氮比例严重失衡,有害藻类和细菌容易滋生,水质底质风险增加。
通过内服有益菌定植肠道、营养保健品修复、提高肠道抗应激能力,抑制弧菌。益生菌持续分解饲料残渣粪便,减少水体有害物积累,抑制弧菌与病毒积累爆发。
2、使用发酵饲料养虾的好处?
(1)虾爱吃:采用高档原料,具有特殊香味,适口性好,虾特别爱吃。
(2)水质好:持续补充微环境碳氮平衡,维持细菌多样性,减少肥水产品投入,培养更多优质天然饵料,有效抑制蓝藻等有害藻类的生长和繁殖,改良水质,三天水质变清亮。
(3)发病少:增强虾的免疫力,减少虾病,提高虾的成活率,在养殖前期效果突出。
(4)消化好:改善虾的肠道环境,肠道变粗,促进饲料的消化吸收,粪少而不臭成条状。
(5)生长快:使用虾多宝,生长速度明显加快,特别是养殖中后期体现更明显,饵料系数降低0.1-0.2,可提前上市。
(6)活力强:使用虾多宝一周后,可见虾的活力明显增强。
(7)应激少:对下雨、打雷、光照、分塘、声音等刺激应激反应少。
(8)体色好:虾体透明,适应市场需求。
(9)回报高:全程使用有效降低饵料系数,缩短养殖周期,节约饲料和能源,提高综合回报。
(10)使用方便:可直接拌料投喂,也可充分混合发酵投喂,减少劳动量,有利于大面积使用。
3、虾多宝使用方法
“泡菌”发酵
池塘泼水补菌:5-7天用一次,一次20斤/亩;
发酵液拌料投喂:配合VC等产品,
干拌投喂:虾多宝按比例与饲料一起加水拌匀,密封饲料袋内下一餐投喂(前期1:1,中期1:5,后期1:10);
直接投喂:对虾白便等不良情况时不宜全部停料,虾多宝代替投喂。
请输入标题 bcdef
【江南养虾人】养虾,全心全意
上海大小棚卖虾第一人,“金钱”组合亩产超1000斤,亩利润超20000元!
再续2017年传奇,我们已经成功了一半!嘉兴沼虾养殖,收货可期
虾苗料变革!这种新型饲料,与天然饵料媲美,比开口料更容易操作
虾苗发白、漂苗、掉苗频发,是什么原因让虾越来越难养?多年实战经验总结,苗期标粗关键点大集合
请输入标题 abcdefg
海大·优秀公司·评选
海大集团成立二十周年系列庆祝活动之工厂巡礼“优秀公司”。扫描如下二维码,即可为您认为的优秀公司投票。



